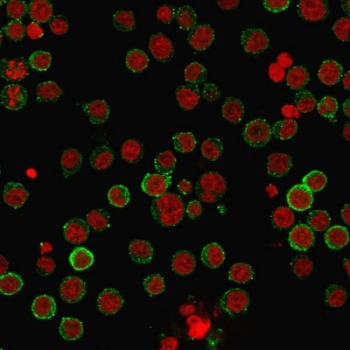
CD45RA Antibody

You have no items in your shopping cart.
CD8 antibody
Description
Images & Validation
−| Tested Applications | ELISA, IHC-P, WB |
|---|---|
| Dilution range | WB: 1:200-800, IHC-P: 1:100-300 (based on 0.5 mg/ml) |
| Application Notes |
Key Properties
−| Host | Rabbit |
|---|---|
| Clonality | Polyclonal |
| Isotype | IgG |
| Immunogen | KLH conjugated synthetic peptide derived from human CD8. Please contact us for the exact immunogen sequence. The peptide is available as orb374713. |
| Target | CD8 |
| Molecular Weight | 26 kDa |
| Purity | Polyclonal antibodies are purified by peptide affinity chromatography |
| Conjugation | Unconjugated |
Storage & Handling
−| Storage | Maintain refrigerated at 2-8°C for up to 2 weeks. For long term storage store at -20°C in small aliquots to prevent freeze-thaw cycles. |
|---|---|
| Form/Appearance | 10 mM PBS, 0.02% sodium azide |
| Concentration | - 100 μg (in 200 μl): 0.5 mg/ml- 200 μg (in 400 μl): 0.5 mg/ml |
| Disclaimer | For research use only |
Alternative Names
−Similar Products
−CD8B Rabbit Polyclonal Antibody [orb1269]
IF, IHC-Fr, IHC-P
Equine, Gallus, Guinea pig, Porcine
Human, Mouse, Rat
Rabbit
Polyclonal
Unconjugated
50 μl, 100 μl, 200 μlCD8 antibody [orb323288]
ELISA, ICC, IF, IHC-P, WB
Human, Mouse, Rat
Rabbit
Polyclonal
Unconjugated
100 μgCD8 Recombinant Rabbit Monoclonal Antibody [orb2563017]
IF, IHC-Fr, IHC-P
Human
Rabbit
Recombinant
Unconjugated
25 μl, 50 μl, 100 μlCD8 Rabbit Polyclonal Antibody [orb312181]
FC
Mouse
Human
Rabbit
Polyclonal
Unconjugated
50 μl, 100 μl, 200 μl

Quality Guarantee
Explore bioreagents carefree to elevate your research. All our products are rigorously tested for performance. If a product does not perform as described on its datasheet, our scientific support team will provide expert troubleshooting, a prompt replacement, or a refund. For full details, please see our Terms & Conditions and Buying Guide. Contact us at [email protected].

Immunohistochemical staining of paraffin embedded rat spleen tissue using CD8 antibody (2.5 ug/ml)

Immunohistochemical staining of human endometrial cancer tissue using anti-CD8 (2.5 ug/ml)

IHC-P image of rat spleen tissue using anti-CD8 (2.5 ug/ml)

Immunohistochemical staining of paraffin embedded human endometrial cancer tissue using anti-CD8 (2.5 ug/ml)

WB analysis of rat thymus (lane 1), rat spleen (lane 2), rat brain (lane 3), human breast cancer (lane 4), human endometrial cancer (lane 5) using CD8 antibody (1 ug/ml)

WB analysis of rat thymus (lane 1) using CD8 antibody (1 ug/ml)

IHC-P image of rat spleen tissue using CD8 antibody (2.5 ug/ml)
Quick Database Links
Documents Download
Request a Document
Protocol Information
Filter by Applications
Filter by Species
Sagkan Ozturk, Aliye et al. Short term effects of experimental gastric outlet obstruction and truncal vagotomy on gut hormones Biotech Histochem, (2021)
Applications
Reactivity
Chien-Chun Steven Pai et al. Clonal Deletion of Tumor-Specific T Cells by Interferon-? Confers Therapeutic Resistance to Combination Immune Checkpoint Blockade Immunity, 50, 477-492.e8 (2019)
Applications
Reactivity
Chen, Xinran et al. Increased B7-H4 expression during esophageal squamous cell carcinogenesis is associated with IL-6/STAT3 signaling pathway activation in mice Oncol Lett, 13, 2207-2215 (2017)
Applications
Reactivity
Prashant, Chandravilas Keshvan et al. Fabrication of nanoadjuvant with poly-ε-caprolactone (PCL) for developing a single-shot vaccine providing prolonged immunity Int J Nanomedicine, 9, 937-950 (2014)
Applications
Reactivity
Pedro Henrique Felix Silva et al. Effects of Bdellovibrio bacteriovorus HD100 on experimental periodontitis in rats Mol Oral Microbiol, 38, 158-170 (2023)
Applications
Reactivity
Hekim, Can et al. Dasatinib Changes Immune Cell Profiles Concomitant with Reduced Tumor Growth in Several Murine Solid Tumor Models Cancer Immunol Res, 5, 157-169 (2017)
Applications
Reactivity
Sadighi, Sanambar et al. Down-regulation of immune checkpoints by doxorubicin and carboplatin-containing neoadjuvant regimens in a murine breast cancer model Iran J Basic Med Sci, 24, 537-544 (2021)
Applications
Reactivity
Annen, Ryohei et al. Tumor-Specific Immunoenhancing Effects after Local Cryoablation for Metastatic Bone Tumor in a Mouse Model Int J Mol Sci, 23, 9445 (2022)
Applications
Reactivity
Ka, Na-Lee et al. IFI16 inhibits DNA repair that potentiates type-I interferon-induced antitumor effects in triple negative breast cancer Cell Rep, 37, 110138 (2021)
CD8 antibody (orb10325)
Participating in our Biorbyt product reviews program enables you to support fellow scientists by sharing your firsthand experience with our products.
Login to Submit a Review